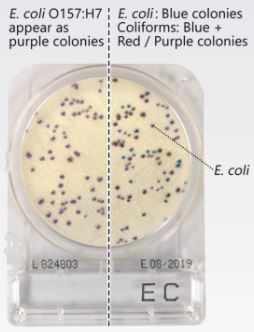

Sample Preparation:

For indicator organisms (TC, EC, YM, XSA, and XBC) - Cut out standardized sample size (e.g. 10g or 25g) using sterile knife or scissors. Place in a sterile container, the add the appropriate volume of sterile diluent (e.g 90ml or 225ml of Buffered Peptone Water or BPW, Maximum Recovery Diluent or MRD, or 0.1% Peptone Water). Homogenize and dilute accrordingly.
For pathogens (SL and LS) - Weigh 25g and dilute with 225ml sterile BPW.
Regulatory limits
Refer to Codex Alimentarius, Food & Drug Administration (FDA), Food Standards Agency (FSA), or other local regulatory bodies
Processing Notes
- Use 25g sample size for samples that absorb a large volume of dilute.
- User filter bags to minimize inclusion of sample particles during inoculation.
Effet of Sample Color to Result Interpretation
Color of the sample may interfere with the interpretation of the results (Figure 1). Plate the highest dilution possible without affecting the needed sensitivity of the test, e.g if allowable level for total count is 800 CFU/g, plate 1ml of the 10-2 dilution (Figure 2) but not 10-3 since it cannot detect the required level.
Sample: Chocolate Muffin
For pathogens (SL and LS) - Weigh 25g and dilute with 225ml sterile BPW.
Regulatory limits
Refer to Codex Alimentarius, Food & Drug Administration (FDA), Food Standards Agency (FSA), or other local regulatory bodies
Processing Notes
- Use 25g sample size for samples that absorb a large volume of dilute.
- User filter bags to minimize inclusion of sample particles during inoculation.
Effet of Sample Color to Result Interpretation
Color of the sample may interfere with the interpretation of the results (Figure 1). Plate the highest dilution possible without affecting the needed sensitivity of the test, e.g if allowable level for total count is 800 CFU/g, plate 1ml of the 10-2 dilution (Figure 2) but not 10-3 since it cannot detect the required level.
Sample: Chocolate Muffin

Similar to other tests that rely on β-Glucuronidase activity to detect E.Coli, CompactDryTM EC cannot detect E.coli O157:H7 as an E.coli.
AZ LAB Co.,LTD is currently the official distributor of Nissui Compact Dry products in Vietnam with all the following criteria: Total Count (TC), E.coli and Colifrom (EC), Enterobacteriae (ETB), Vibrio parahaemolyticus (VP), Bacillus cereus (X-BC), Yeast & Mold (YM), Staphylococcus aureus (XSA), Enterococcus (ETC), Pseudomonas aeruginosa (PA), Salmonella (SL), and Listeria.
All information about Compact Dry products, customers can see at:
All information about Compact Dry products, customers can see at:
Reader Comments
You must login to comment this article










